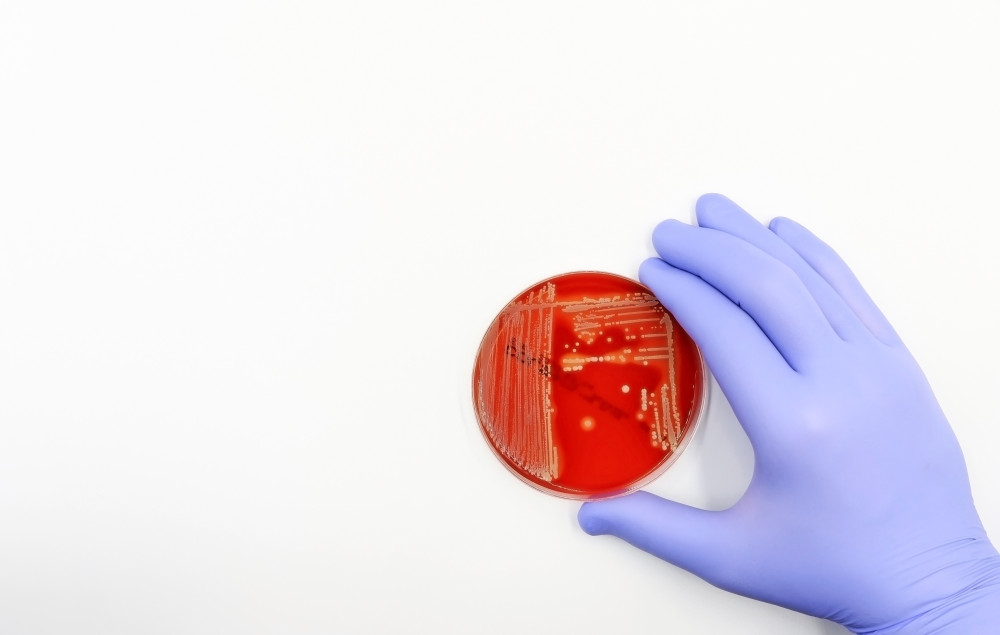

![]() |
To date, there is no device for the effective removal of fp-Hb from the blood. An ideal device should specifically bind Hb dimers and tetramers in high quantities and without any interaction with other plasma components. To design a device with such specificity (and high load capacity), we will draw inspiration from a strategy exploited by bacteria to capture the iron present within hemoglobin when they infect humans. In fact, several pathogens exploit iron, which is a fundamental nutrient for them, by extracting it from hemoglobin to survive and proliferate. Among these there is Staphylococcus aureus, a pathogen that is able to induce the rupture of red blood cells, intercept the fp-Hb and extract the heme (within which there is iron) through two proteins, called IsdB and IsdH, which are anchored on the cell wall of the bacterium. In particular, the structure of the complex that the IsdB protein forms with human hemoglobin (https://www.rcsb.org/structure/7PCH) has recently been solved through electron cryomicroscopy (cryoEM), providing a structural model suitable for the development of molecules capable of sequestering fp-Hb from plasma. |
|
| However, the use of this entire protein, expressed recombinantly, is hampered by the large quantities required and by its instability when isolated from the bacterium wall. Peptides, on the other hand, are exact copies of protein fragments that can be synthesized to mimic the hemoglobin binding properties of IsdB and represent a powerful tool to solve these problems, also introducing further chemical modifications (peptidomimetics) to improve their characteristics for the purposes of this therapeutic application. | ![]() |
|
![]() |
Peptides or peptidomimetics capable of mimicking the properties of IsdB in terms of binding to hemoglobin can then be conjugated onto a plasma filter support, based on mesoporous silica nanoparticles (MSN). MSNs have attracted great interest in both nanomedicine and nanotechnology due to their large pore volume, huge surface area, and tailorable pore diameter. The peptide-functionalized MSNs will then be packaged in a plastic housing simulating a hemoperfusion module and tested for their ability to bind Hb in buffer solutions and hemolyzed plasma samples. The device will represent a feasibility test of the possibility of producing an Hb binding module for extracorporeal blood treatment. |
|